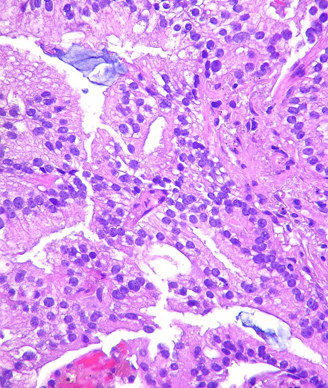

A large retrospective analysis suggests the number of patients diagnosed with intermediate- and high-risk prostate cancer has increased since 2011.
Metastatic prostate cancer, mucinous; source: Yale Rosen, Wikimedia Commons
A large retrospective analysis of men treated for prostate cancer since 2005 suggested an increase in the number of intermediate- and high-risk cancers diagnosed between 2011 and 2013. The proportion of men diagnosed with higher-risk tumors increased by 3% each year (P < .0004). These study results (Abstract 143) were presented at a press conference in advance of the 2015 Genitourinary Cancers Symposium by study author Timothy E. Schultheiss, PhD, director of radiation physics at City of Hope in Duarte, California.
Schultheiss and colleagues analyzed retrospective data from 87,562 men diagnosed with prostate cancer between 2005 and 2013. The data were collected from the National Oncology Data Alliance, a proprietary database of more than 150 hospitals across the United States.
The authors emphasized that these data are preliminary and that further studies are needed to understand these observed trends.
Intermediate- or high-risk disease was defined as a blood prostate-specific antigen (PSA) level greater than 10, irrespective of tumor grade or stage of disease, at the time of diagnosis. According to Schultheiss, about one-half to two-thirds of men with a PSA level greater than 10 at screening are diagnosed with prostate cancer.
The proportion of prostate cancer patients with a PSA level greater than 10 decreased gradually between 2005 and 2011 but then increased between 2011 and 2013, according to the study.
In 2009, the US Preventive Services Task Force (USPSTF) recommended that PSA not be used for prostate cancer screening in men that are 75 years of age or older. In 2011, they updated the recommendation to exclude PSA screening for all men, irrespective of age.
Data using Gleason score, tumor stage, and PSA level to categorize patients based on the National Comprehensive Cancer Network (NCCN) risk group showed the same downward trend between 2005 and 2011 and an increase in higher-risk prostate cancer between 2011 and 2013. Using this risk group, the percentage of men with intermediate- or high-risk cancer was about 70% to 73% before 2011, and increased by 2.9% in 2012 and 2013 (P < .003).
With an estimated 233,000 new cases of prostate cancer diagnosed in 2014, this data suggests that about 14,000 men will go from a low- to higher-risk disease group.
Whether this effect can be attributed to the USPSTF recommendation changes in 2009 and 2011 is still speculative, said Schultheiss. He noted that European and American randomized studies have shown a survival advantage for men who undergo screening compared with those who do not and that both the American Society of Clinical Oncology and the NCCN include PSA screening in their prostate cancer screening recommendations.
This study adds to the debate on prostate cancer screening and underscores the importance of continuing to study the issue of changing guidelines, said press conference moderator Charles Ryan, MD, program leader of genitourinary medical oncology at the University of California, San Francisco.
The study authors plan to update this analysis with new registry data on prostate cancer patients as it becomes available.